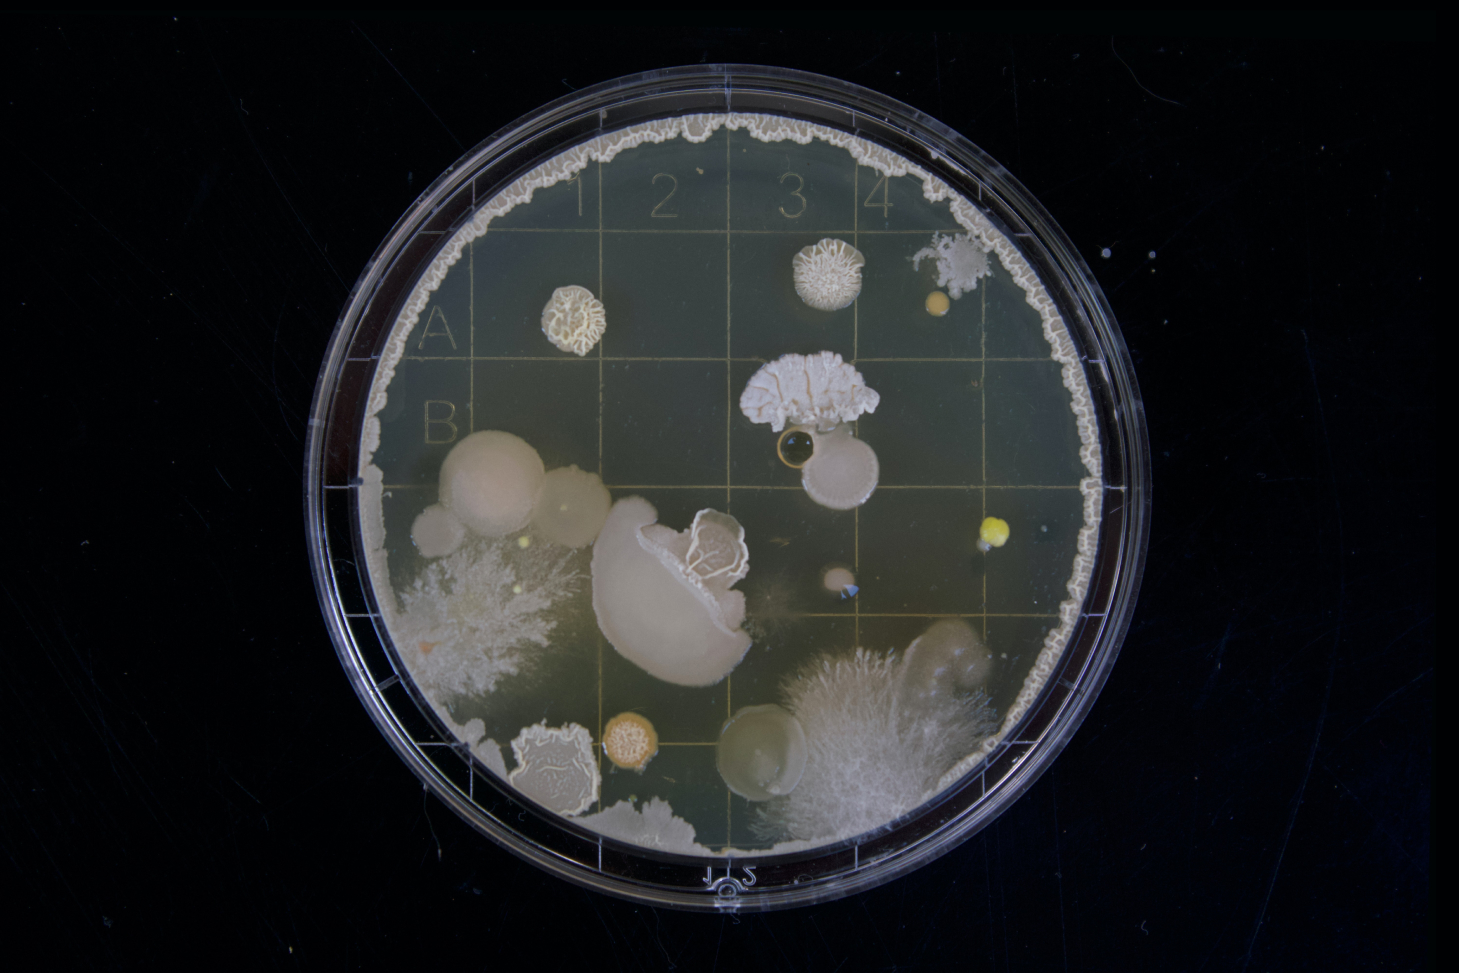

TIBIOLab is a company active in biotechnological production of microorganisms for the environmental and food fields, chemical and microbiological analysis, and R&D activities on behalf of Frattale Group companies.
TIBIOLab is a company active in biotechnological production of microorganisms for the environmental and food fields, chemical and microbiological analysis, and R&D activities on behalf of Frattale Group companies.